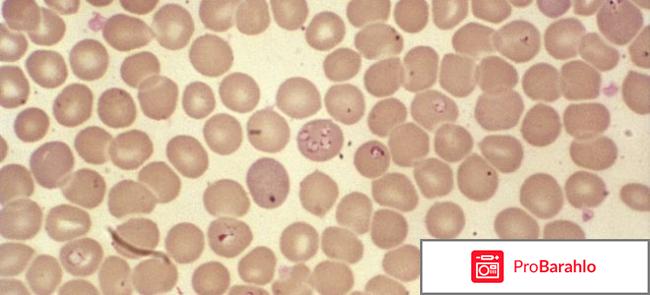
Бабезиоз у человека симптомы и лечение отрицательные отзывы

Разное (красота и здоровье) - отзывы покупателей о товарах

Боль и Траумель
Когда человек травмируется, то любая травма сопровождается болью или другими неприятными ощущениями, от которых хочется избавиться как можно быстрее. Так как при любой травме происходит то, что ткани также травмируются, повреждаются, или могут начать развиваться патологии в опор-но двигательной системе. На самом деле, получить различного рода травму человек может абсолютно в любом месте, даже просто слегка споткнуться или неправильно повернуть свое тело. Также, болевые ощущения могут проявляться, когда у человека обостряются хронические заболевания в опорно-двигательном аппарате. Тогда лечение поможет правильно подобрать врач, так как он должен выявить причину боли, и уже тогда подбирать необходимые и соответствующие препараты, которые помогут не просто убрать боль, но и восстановить полученное повреждение, чтобы не привести к развитию различного рода осложнений. Сейчас есть множество препаратов, которые позволяют снимать болевые ощущения, среди них отличное средство, которое помогает без негативных последствий для организма, это Траумель таблетки.

Траумель имеет несколько форм выпуска. Состав препарата полностью растительный, поэтому он полностью для организма безопасен. Но это не такие таблетки, к которым мы привыкли. В данном случае их нельзя проглатывать и запивать сразу водой. Таблетка кладется в рот и постепенно рассасывается. Препарат позволяет оказывать на организм комплексное действие: снимает воспалительный процесс, отличный анальгетик, оказывает противоэкссудативное действие, реперетивный эффект, позволяет оказывать иммунокорректирующее действие.
С данным препаратом я познакомилась совсем неожиданно для себя. Назначил мне его мой гинеколог. Он объяснил, что данный препарат отлично помогает в комплексе с другими средствами, когда есть различные воспалительные процессы. Препарат не оказывает быстрый эффект, так как это гомеопатия и эффект проявится через время. По вкусу таблеточки приятные сладкие, это очень хорошо, так как их необходимо рассасывать. Это процесс не долгий, так как растворяются они достаточно быстро под языком. Принимаются таблетки до еды, за минут пятнадцать. Изначально переживала, что принимая препарат на голодный желудок, они могут вызвать расстройства ЖКТ, но как оказалось, никаких проблем.
Одной упаковочки мне хватило на курс приема - две недели. В комплексе, препарат оказал отличный эффект. Но если таблетки принимать отдельно, то результат будет дольше, так как это гомеопатия. Состав их отличный, там только травы. Никаких аллергий и других нарушений у меня не возникало за период приема данного препарата.

Когда необходимо принимать препарат
Траумель рекомендуется к применению в таких случаях:
- препарат отлично помогает, когда произошли повреждения в тканях после различных травм, не зависимо от причины, по которой они появились.
- при сотрясениях в головном мозге.
- при различных заболеваниях или проблемах в опорно-двигательном аппарате.
- остеохондроз.
- назначаются таблетки в области стоматологии.

Противопоказания таблеток
Траумель имеет также свои противопоказания:
- повышенная чувствительность или непереносимость каких-то компонентов средства,
- если у человека есть склонность к различного рода аллергиям,
- препарат не рекомендуется принимать при наличии заболевания - коллагеноз,
- противопоказанием также является и склероз рассеянный,
- лейкоз - строгие противопоказания в этом случае,
- при аутоимунных нарушениях, туберкулезе,
- при недостаточности в организме лактозы.

К счастью уходят те времена, когда девушек в двадцать лет гнали замуж и призывали до двадцати пяти лет успеть родить первого ребенка. Однако, внутри каждой из нас сидит та самая вредная бабка, которая нашептывает, "торопись родить, потом не успеешь". Современная жизнь стала более динамичной, женщины стремятся вкладывать как можно больше времени в свое образование и построение карьеры, оставляя семью и детей на более удачное время. Некоторые не вступают в брак и не рожают потому, что ищут настоящей любви, качественных отношений. Конечно же, биологические часы есть у каждой из нас, и каждый прожитый год способствует лишь старению и делает чуть менее возможным быстрое зачатие и успешное вынашивание ребенка.
В Европе женщины в среднем рожают первых детей в возрасте от 325 до 40 лет. При хорошем уровне медицинского обслуживания, зачатие и вынашивание проходит успешно, рождаются здоровые дети. Это норма, и никто не скажет "она поздно родила". Если женщина живет здоровой жизнью, отказывается от вредных привычек, то она долго сохраняет здоровые яйцеклетки и может рожать. В России также постепенно сдвигается возрастная планка рождения ребенка, и все чаще женщины рожают первых и следующих детей после сорока лет.

Особенности беременности после сорока лет.
Сорок лет - это отличный возраст в жизни любого человека. Еще тридцать лет назад в этом возрасте женщины становились бабушками и шли нянчить первых внуков, а сейчас в этом возрасте настоящий расцвет жизни. Женщины выстраивают карьеру, успешно выходят замуж и беременеют. Родить в сорок вовсе не поздно. В этом возрасте женщина, следящая за собой, еще очень молода и сильна. Кроме прочего, более старшие женщины уже более обдуманно подходят к планированию собственной жизни и к беременности в том числе.

Однако, следует понимать, что после сорока лет, у каждой женщины в той или иной степени происходят возрастные изменения в репродуктивной системе, и в организме в целом, поэтому так важно вовремя проходить все рекомендованные медицинские обследования и исполнять все предписания наблюдающего врача.
Беременность после 40 лет отзывы врачей.
Беременность после сорока лет для врачей стала вполне обыденным явлением. Они ведут беременность буквально от момента планирования и зачатия до родов. Есть множество отличных современных медицинских препаратов, позволяющих сохранить беременность в случае угрозы. Среди рисков для самой женщины беременность после 40 содержит:
многоплодную беременность - предполагающую нагрузку на организм,
риск вынашивания многовесного или маловесного плода,
обострение или возникновение хронических и других заболеваний во время беременности,
рождение детей с генетическими заболеваниями, как например синдром Дауна.
сильный токсикоз и снижение физической продуктивности и активности,
Родоразрешение беременных в возрасте от сорока лет чаще всего осуществляется путем кесарева сечения.

В любом случае, в сорок лет с огромной вероятностью можно родить здорового, хорошего ребенка, который принесет много радости в жизнь семьи и конечно самой женщины. Современное медицинское оборудование, четко продуманное ведение беременности, здоровый образ жизни, правильное питание позволят сделать этот период приятным. Регулярный прием витаминов позволит сохранить свое здоровье и здоровье ребенка.
Не бойтесь рожать,это прекрасно . Если подходить к этому с умом, все пройдет отлично. и не важно, что за спиной будут шептаться. главное, чтобы ребенок родился здоровым, а матери хватило сил на восстановление и воспитание малыша.

Что такое 
Алкоголизм это зависимость от которой либо надо и хочется избавиться и находить методы лечения, либо же оставить все как есть. Алкоголизм может быть вызван разными факторами и причинами. например наследственность, стрессовые частые ситуации, скучное время провождение и алкоголизм как способ само выражаться или же зависимость может быть из-за плохой компании.
Учитывая факторы и причины алкоголики могут завязать с этой проблемой не только силой воли и специальными дорогими кодировками, которые если опять начать усугубят зависимость , а также можно попробовать средство которое не является медицинским препаратом и называется оно копринол. Это не лекарство и не имеет оно химический состав, а это биологически активная добавка, которая имеет состав в полне натуральный и не наносит вашему здоровью вред и не вызывает побочных эффектов кроме таких как повышенная чувствительность к некоторым из натуральных компонентов в данном средстве от алкогольной зависимости.
В этой статье мы рассмотрим как и где купить препарат как принимать и в чем его основные преимуществ а и конечно же каков состав данного чудо средств а от избавления от алкогольной зависимости.
Копринол 
Копринол это название препарата и латинскими буквами название препарата выглядит так Caprinol или Coprinus что в переводе означает некий гриб, который по нашему считается просто навозным белым грибом. Данный гриб и его экстракт в составе данного средства и позволяет завязать с алкоголем. Так как такой гриб не смертельный но отравление им опасно и не очень приятно, особенно данный гриб действует в работе с алкогольными напитками с высоким содержанием в нем спирта. Выпивая даже маленькую дозу и при этом проходя курс лечения данной активной биологической добавкой ваш организм будет сильно отравлен а работа желудочно-кишечного тракта будет хуже и медленно.
Также в составе есть дополнительные компоненты которые стабилизируют всю работу организма насыщая его необходимыми минералами и витаминами, в составе данного препарата от алкоголизма копринол.
Если в нормальных пропорциях и по указаниям пить данное средство то организм в добавок от алкоголизма еще и нормализует стабильную и функционирующую работу почек и печени, таким образом такую биологически активную добавку можно считать действенной при лечении от зависимости принятия алкогольных напитков.
Как действует
Копринол выпускается форме капель и саше, а также активно помогает при затянутом алкоголизме и только при начальном этапе алкоголизма.
Копринол стоит пить курсом и уже на 3 день будут видны результаты, так как гриб в составе начинает реагировать на принятый вам алкоголь и вызывает очень сильную тошноту и рвоту.
Если же у вас имеются расстройства в нервной системе и заболевания психологического характера, имеются язвы желудка, чувствительность повышенная, эпилепсия и много других как правило хронических заболеваний то данный препарат от алкоголизма копринол вам просто противопоказано употреблять.
Если же вы не нашли копринол в аптеке то есть много как более дешевых так и более дорогих аналогов данного средства для лечения алкоголизма.
Даже смотря отзывы в основном этот препарат пьют мужчины и жены их довольны, так как говорят очень быстро наступает эффект от лечения и уже если еще и тянет на алкогольные напитки, то многие думают перед выпивкой о последствиях если уже начал пить курс капель или суспензии копринол.
Если аналог можно купить за 100 или 200 рублей, то копринол стоит очень дорого до 50 тысяч рублей может доходить курс полного лечения алкоголизма с копринол.

Так выглядит сама упаковка.
После покраски волосы просто блестят! Очень красивые, густые волосы.
Цвет волос просто изумителен!
Краска на голове может держаться примерно 5-7 месяцев.
Буква N на упаковке, означает то, что цвет натуральный. Как-то так. Но натуральный оттенок в красках, не всегда красивый, но мне понравился цвет, даже очень! Он непонятный, он изумительный! Я в восторге от краски. Настоящие профессиональные, хочу подметить, колористы, редко кладут немного красноватого оттенка. Чтобы убрать зелень, которая появляется при покраски волос. Только в тёмный цветах (не светлых!).
Существует ещё много хороших красок, но мне нравится именно Палет.
Например, вот благодаря этой краски, цвет тоже не плохой.
Цвет получается блестящий, красненький такой. Тоже не плохой цвет получается. Я довольна краской!
Цена низкая, стоит всего 138 рублей, я,подумала, и решилась купить эту краску.
Что я хочу сказать о этой краске, она конечно хорошая, но её мало. Мне с трудом хватило краски на мои волосы!! Но цвет получается конечно же хороший. Я довольна. Вот так. Краска очень даже хорошая, а главное, дешёвая, но плохо, что её мало. На длинные волосы хватит не всем. Экономьте!



Я пересмотрела много информации, по поводу компрессорных небулайзеров, но выбрала именно этот, фирмы Gamma, для всей семьи, так как он идеален, по крайней мере на мое мнение.
Если быть точным, то данный аппарат называется
Компрессорный ингалятор для всей семьи Family (Gamma). Покупала ингалятор я больше трех лет назад, в аптеке. Сейчас вижу в продаже во многих аптеках, фирма довольно таки популярна.
Ингалятор выглядит стильно, в нем нет ничего лишнего.
Нужно помнить, что это не игрушка, аппарат серьезный, и очень необходим при лечении не только ребенка, но и всей семьи. Поэтому не оставлять его без присмотра с детьми, что бы ребенок не разбил. Так же следить за тем, где он стоит, что бы не упал.
В коробке к нему есть инструкция. Я бы советовала сразу перечитать, что бы полностью знать что можно делать, а что нельзя.
На различных форумах я читала ответы и комментарии, где мамы советуют дышать эфирными маслами, или настойками. И прихожу от этого в ужас! Ведь если ознакомится с аппаратом, будешь знать, что категорически запрещено использовать масла в ингаляторе! Стоит только 1 раз залить масло, и все, его можно будет выкинуть. Довольно так дорого обойдется ваша ошибка!
В ингаляторе, компрессорном небулайзере, можно использовать только растворы. Можно так же использовать физ раствор, и воду, такую как Боржоми. Все, больше ничего нельзя.
С чего же состоит данный ингалятор.
Сам аппарат
трубка силиконовая
насадки (2 маски, насадка для рта, и носа)
заменные фильтры
колба для лекарства
Перед тем, как применять аппарат, его необходимо правильно собрать.
Даже если вы не посмотрите инструкцию, его можно легко собрать. По другому его никак не собрать.
Аппарат-силиконовая прозрачная трубка - емкость для лекарства - и маска. Вот такой порядок.
Ингалятор я использую для лечения кашля, в основном ребенку, и себе. Для этого использую назначенные средства нашим лечащим врачом. Это Лазован, Амбробене, Вентолин, Флексотид, Беродуал, Декасан, вода Боржоми.
Естественно это не полный список лекарств, которое можно использовать.
С помощью ингалятора кашель быстро переходит в мокрый, и ребенок начинает откашливать мокроту. Болезнь начинает проходить.
Так же при насморке включаю ингалятор, наливаю физ раствора, и даю дышать. Так раза 2-3 в день.
Отлично помогает убрать насморк.
Своей покупкой остались довольны. Поэтому и вам советую.
Компрессорный ингалятор для всей семьи Family (Gamma) цена около 700 грн

Намечалось день рождение у моего старшего брата и хотелось сделать ему какой-то уникальный и неповторимый подарок, чтобы он ему запомнился. Он у меня молодой человек достаточно капризный и в плане подарков ему достаточно сложно угодить. Так как он давно уже коллекционирует различный плакаты с изображениями
Pin up girls, то решила, что и подарок будет из этой области. Не знала в начале что же означает этот термин, а оказалось, то это просто изображения девушек в основном не плакатах и карточках. Это не просто девушки, а известные модели. бывшие или ныне действующие популярные актрисы, модели подиума или просто светские львицы.

Мама моя всячески против выступала подобному увлечению своего сына и постоянно шутила по этому поводу. Но я бы не назвала этой какой-то формой озабоченности, потому что на плакатах и изображениях с
Pin up girls девушки нормально одеты и все их прелести спрятаны от посторонних глаз. Эти девушки прекрасная ходячая реклама того, как действительно должна выглядеть нормальная и здоровая девушка. Ни разу еще не довелось видеть девушку в стиле
Pin up girls с чрезмерной худобой. Все девушки этого направления с довольно пышными формами, но и не толстые, а в средней комплекции тела. Вот если бы вместо худых и замученных красавиц после диет, таких как Кира Найтли и Кейт Мосс, чаще висели плакаты с
Pin up girls, то взгляды на женскую фигуру сейчас бы были совершенно другими. Так же здесь другое представление не только на параметры тела, но и на бюст. Девушки формата
Pin up girls обладают совершенно разными формами от маленького и до большого размера груди.
Еще одно отличие девушек с таких плакатов в том, что не все они признанные красавицы, я довольно часто видела плакаты с ними, где они смотрятся, как обычные и мало привлекательные девушки.
Вообще это ретро стиль и я даже помню плакат в стиле
Pin up girls, где изображена Монро с бутылкой колы на пляже. Еще есть слухи, что это не Норма Джин Бейкер, но как знать.
Девушки на таких плакатах предстают в самых разных профессиях и хобби. Можно здесь встретить парикмахера, модель, стюардессу, девушку с мороженым, циркачку и многих других.
Макияж не такой у них яркий, как у современных девушках. Это не пропаганда чего-то пошлого, а просто красивые девушки, но все же есть в таких плакатах фривольный стиль, но все сделано со вкусом.
Брат был в восторге от плаката с
Pin up girls и пополнил свою многочисленную коллекцию.

Климактерический синдром у многих женщин отмечается очень ярко - понижение настроения, депрессивные состояния, бессонница, головные боли, нервозность, частые "приливы". Женщинам приходится очень тяжело, поэтому они бывают грубыми и резкими, и их близким людям приходится с пониманием относится к таким возрастным изменениям.
В настоящее время ведущие ученые компании Эвалар сумели приобрести такое средство, которое налаживает работу организма в столь сложный для него период - Циклим бережно относится к организму, восполняет недостаток полезных средств и сглаживает проявления климакса.

Циклим
О средстве
Циклим - лекарственное средство исключительно растительного происхождения, разработанное компанией Эвалар, создано специально для людей, находящихся в климактерическим периоде.
Циклим является негормональным средством - в его составе только природные компоненты, которые налаживают естественный для человека гормональный фон, благодаря чего состояние организма стабилизируется.

Состав препарата
Активное натуральное вещество под названием цимицифуга способно положительно повлиять на гормональный фон - его эстагеноподбное действие наладит нехватку женского гормона, а значит приведет гормональный фон в норму.
Микрокристаллическая целлюлоза (данный компонент является вспомогательным) поможет женщинам и мужчинам климактерического возраста не толстеть и оставаться всегда в хорошей форме. Данный компонент дарит состояние насыщения и несколько подавляет аппетит.
В основном составе можно увидеть витамины, магний, кальций, цинк, селен и фолиевую кислоту, а также экстракт пустырника, который призван успокоить человека, унять нервозность и наладить хороший сон.

Отзывы врачей
О лекарственном средстве Циклим можно прочитать отзывы врачей, которые имеют свое мнение относительно данного средства и его воздействия на организм человека в климактерический период.
Г. П. Смирнов, врач-терапевт
Я как терапевт могу сказать, что многие женщины приносили мне это средство и спрашивали моего совета.
В составе я не нашел ничего плохого, по составу видно, что производители знают особенности организма в этот сложный период, поэтому добавили туда как можно больше необходимых микроэлементов и витаминов.
Циклим - известное средство, которое принимают сотни тысяч людей в настоящее время. Отрицательных результатов приема нет, побочных действий отмечено не было. Сами пациенты отмечают повышение настроения и хороший сон. Значит, я могу посоветовать Циклим к применению.

А. Я. Телеченко, врач-терапевт
Самым главным положительным качеством Циклим я могу отметить его уникальную возможность корректировать гормональный фон в верном направлении, будучи совершенно негормональным средством.
Так что людям приходится пить гормоны чтобы поправить здоровье. Здесь же Циклим предлагает нам оздоровиться, откорректировать гормональный фон (который как раз шатается в это время жизни человека), но само средство полностью натуральное, а коррекция фона гормонального происходит благодаря верному сочетанию природных компонентов.
Я всем своим пациенткам, достигшим возраста в 43-45 лет советую пропить пару курсов Циклим - отличное средство, которое позаботится о здоровье человека перед наступлением климакса и во время менопаузы.
Циклим - средство, рекомендованное врачами
Как видно, врачи рекомендуют своим пациентам лекарственное средство Циклим, а значит его можно принимать без опаски.
Циклим от Эвалар можно приобрести как оформив заказ по интернет-магазину или на официальном сайте, так и в аптеках.


Русские мужчины вошли в ТОП 3 самых некрасивых мужчин в мире. И что греха таить это правда. Кроме того, что они часто по генетическим причинам не могут похвастаться приятным лицом, красивыми волосами, высоким ростом, хорошим телом, они со своей стороны вовсе не пытаются выглядеть хоть чуточку лучше. Спортзал - увольте, это для избранных. Куда лучше открывать дверь отвислым пузом и почесывать потные, волосатые сиськи на диване. Типичная стрижка гопника дополняет образ каждого ПАЦАНА из провинции. В довершении к ужасной внешности, запущенному телу еще можно добавить совершенное не желание заниматься собственной гигиеной.
Наши мужчины жутко выглядят, воняют потом, пивом, мерзкими сигаретами, сияют гнилыми зубами, сыплют перхотью, а в гостях могут просто сразить вонью потных ног. И я ничуть не преувеличиваю, это наша реальность. И если не кривить душой, испытывать сексуальное влечение к таким мужчинам просто физически не возможно. Женщины конечно решаются на эти контакты. Но, зачастую виной тому банальное одиночество, жажда финансовой выгоды, брачные обязательство. Но никак не естественное физическое сексуальное желание. Женщина не испытывающая сексуального желания к своему мужчине ищет причину в себе. Хотя она вовсе не в ней. А иногда даже решается попробовать женские возбудители.

Женский возбудитель.
Женский возбудитель - это своеобразный допинг, который выпускается в различных формах и служит для стимуляции у женщины сексуального влечения и желания. Естественно, что такие средства не являются натуральными и служат в основном для приема внутрь. Среди наиболее популярных средств для женского возбуждения можно выделить "Серебряную лису", "Женскую виагру", "Конский возбудитель", "Возбудитель форте". С ними любят экспериментировать мужчины, которые в некоторых случаях даже тайком от самой женщины могут подлить ей этого самого средства.
Возбудители для женщин выпускаются в виде капель для приема внутрь. Также в виде кремов и гелей, которые вызывают приток крови к половым органам и стимулируют возбуждение. Есть также народные рецепты возбудителей, которые готовят из различных продуктов питания и принимают внутрь. Их действие менее выраженное и более мягкое, а также часто одним из компонентов является алкоголь.

Ну и наиболее мягким средством можно считать духи с феромонами и продукты афродизиаки.
Самый хороший женский возбудитель.
Самый хороший женский возбудитель - это качественный, сексуальный мужчина. Если это не ваш случай, и ваш мужчина как водится чуть покрасивее обезьяны, для начала стоит задуматься, а стоит ли секс вообще экспериментов с непонятными химическими средствами, которые производятся из странных компонентов и могут нанести непоправимый вред здоровью в долгосрочной перспективе.
На мой взгляд, стоит избегать всех промышленных возбудителей. Это чревато аллергией, нарушениями работы органов и систем организма.

Если использовать менее агрессивные средства. То, в качестве возбудителя может подойти легкий алкогольный напиток в небольших количествах. Из продуктов афродизиаков можно выделить морекпродукты, все свежие ягоды и фрукты, натуральные соки, горький шоколад, зелень, авокадо и другие продукты. Ну и на худой конец, каждая может использовать свой мозг и во время контакта со своим несексуальным мужичком представлять например, Джерарада Батлера или Ченинга Татума в их лучшей форме. Главное, чтобы ваш мужчина в этот момент не заподозрил того, что ваши мысли очень далеки от него. Любите себя и заботьтесь о себе, и учите мужчин уважать себя и вас.

Доброго времени суток всем пишущим интересные и полезные ,самые замечательные и правдивые,основанные лишь на личном опыте ,на собственных знаниях и собственных впечатлениях,о самых различных товарах,услугах,сайтах,организациях.
Приветствую так же всех благодарных,эмоциональных,честных читателей отзывов,которые не остаются равнодушными и всегда дочитываю отзыв до конца и делятся своими впечатлениями в комментариях к отзыву,в которых высказываю свое мнение и оно не всегда на все сто процентов совпадает с мнением автора и надо сказать ,что это замечательно.Всегда очень интересно выслушать мнение ,которое отличается от собственного.
В этом своем небольшом отзыве статье хочу с вами поделится своими небольшими знаниями и впечатлениями после применения крема "Жабий камень".Использовала я его достаточно длительное время,да и в настоящее время прибегаю к его использованию.
Трава Жабий камень - что это такое?
Это небольшое растение из семейства лютиковых ,которое произростает на сырах болотистых лугах.В народе его еще называют "чистяк".В его составе имеется много калиевой соли,которая в нашем организме отвечает за обмен минералов в организме.
Фото смотрите ниже.

Жабий камень это растение ,которые с очень древних времен используется для лечения самых различных заболеваний суставов.
Название конечно же очень странное у травы,но однако это растение очень популярно с древних времен и до настоящего времени у травников и фитотерапевтов именно для таких заболеваний ,как самые разнообразные заболевания суставов и укрепления мышечного каркаса.
жабий камень так же помогает ослабить болевые ощущения,ускоряет реабелитациооный и востоновительный процесс костной и хрящевой тканей после различных травм,снимает отеки.
Фармацевтическая промышленность выпускает жабий камень в двух видах.Это в виде капсул и в виде кремов.Я расскажу вам немного именно о кремах,так как капсулы не принимала и опыта в их применении у меня нет.
Крема


в составе которых присутствует растение Жабий камень.
Крем "Жабий камень с маслом рыжика" (именно его я использовала,продается в основном в аптечных пунктах,в каких - либо магазинах различных косметических товаров я его не видела.
По стоимости я считаю что этот крем совершенно не дорогой .Его цена примерно сто двадцать - сто тридцать рублей за тюбик весом пятьдесят грамм.Это согласитесь в наше время совершенно недорого.
Я достаточно длительное время пользовалась кремом для лечения суставов.Но скорее не так для лечения именно кремом .а как одним из вспомогательных средств при комплексном лечении .
Крем продается в пластиковых тюбиках,которые еще дополнительно упакованы в коробочку.На коробке есть полная информация по составу крема,его фармакологическим свойствам,срок хранения и самые различные рекомендации по применению.так же внутрь вложена более подробная инструкция по приме мнению крема.
Состав кремов.
Если прочитать состав крема "Жабий камень",то можно заметить что на первом месте в составе находится масло рыжика,соответственно этого составляющего больше всего в креме.Это масляничное растение ,которое растет в горах,например в Альпах,в горах Кавказа ,в Армении.В этом масле большое содержание витамина Е,а так же витамины К ,А ,D,свободные радикалы и хролофилл.Все эти вещества усиливают углеводный обмен в нашем организме,а так же способствуют расслаблению мышечного каркаса.
На втором месте стоит основной продукт,название от которого и получил сам крем ,то жабий камень.О его свойствах я уже писала выше.
Так же в составе присутствуют такие вещества,как корень сельдерея,экстракты сабельника и эвкалипта,Камфорное масло и красный жгучий перец.
Рекомендации и инструкция по применению.
 Наносить крем рекомендуется два раза в день,лучше утром и вечером.Наносится его небольшое количество на больное место и втирается легкими массирующими движениями.
Наносить крем рекомендуется два раза в день,лучше утром и вечером.Наносится его небольшое количество на больное место и втирается легкими массирующими движениями.
Не смотря на то ,что в креме присутствует достаточно много веществ имеющий характерный запах,запаха у крема практически нет и наносится он легко,быстро впитывается.Сильного жжения или разогревающего эффекта так же не наблюдается.
Поэтому его можно втирать в боьные места и днем.Сильного запаха или неприятных ощущений не буде.
Советую вам попробовать и составить свое мнение об этом креме.

Ох, уж эти наши волосы. Сколько забот они нам доставляют, красивые и ухоженные волосы во все времена были предметом гордости женщин. На красивые волосы всегда обращают внимание, ими восхищаются, в некоторых случаях даже завидуют. Но сколько же много опасностей их подстерегает в наше стремительное и высоко технологическое время. Мы пользуемся горячими фенами, которые их безжалостно высушивают, используем для окрашивания агрессивные краски, которые также не могут способствовать здоровью волос. Кто-то делает начес, безжалостно нанося повреждения им расческой, а кто-то наоборот использует горячий утюжок для распрямления. Многие увлекаются различными типами завивок. Все эти процедуры превращают нашу шикарную шевелюру в тусклые, непослушные и очень жесткие волосы.
Конечно, локоны, которые не знали утюжков, фенов и завивок самые здоровые, но это не означает, что от них надо полностью отказаться, да это и невозможно. Во всем надо знать меру и правильно использовать косметику для волос, а также правильно ухаживать за ними. Регулярное мытье, правильное расчесывание, качественная косметика для волос, своевременное подстригание расщепленных кончиков, правильное питание и защита от воздействия внешних факторов, помогут нашим прекрасным локонам оставаться всегда красивы, здоровыми и ухоженными.
Сейчас существует большой выбор качественных средств по уходу за волосами. Этусамуюразнообразную косметику выпускают различные фирмы. Одной из таких фирм, выпускающих хорошую и качественную косметику, является Nivea. Их косметическими средствами пользуюсь очень долгое время. Недавно купила себе комплект, состоящий изшампуняи бальзама,у негоочень необычноеназвание"Молочко для волос". Сейчас расскажу освоихвпечатленияхо комплекте.

Описание комплекта.

Производитель обещает настоящее быстрое восстановление локонов без их утяжеления. Продается этот набор в красивой коробочке фирменного синего цвета. В ней упакованы два флакона емкостью по двести пятьдесят миллилитров и двести миллилитров. Цвет у них синий. На флаконах есть различная необходимая информация о продукции. В одном флаконе находится шампунь, а во втором бальзам. Крышки у флаконов открываются с небольшим усилием, они откидные,необходимо нажатие и слышен щелчок. Впрочем,открывать и закрывать довольно удобно.
Цвет у шампуня и бальзама-кондиционера молочно-белый. Консистенция довольно густая. Запах оченьнасыщенный и восхитительный. Аромат еще долгое время остается на волосах. Шампунь отлично пенится, расход его небольшой. Волосы промываются прекрасно после двух раз нанесения. Пена очень ароматная и приятная. Бальзам тоже белого цвета с плотной консистенцией, прекрасно наносится на волосы, отлично распределяется по всей длине, смывается просто великолепно.
После применения средств мои волосы прекрасно себя чувствуют. Они блестят, очень легко расчесываются,становятсямягкими и объемными. Ухаживающийкомплексменя очень приятно удивил и понравился.
Состав и мнения пользователей.

В этой линейке ухаживающих средств, производитель объединяет эффект,который создаютмолочныепротеины и эффектнового увлажняющего и питающегокомпонента с названием - эвцерит.Также входит комплекс витаминов группы В, они как бы каждый волосок окутывают пленкой, защищающей от всевозможных плохих факторов. Коллаген вырабатывается с помощью молочных кислот, он делает волосы упругими и сильными. За укрепление корней и волосяных луковиц отвечает кальций.
Отзывы на эти средства ухода положительные. Все отмечают хорошо промытые волосы, блеск и мягкость, наличие ухаживающегокомплекта для различных типов волос, отличное расчесывание, хороший объем.

Лечение с помощью средств гомеопатии
Лечение с помощью средств гомеопатии уже долгие годы применяется разными людьми. Особенно часто к таким препаратам прибегают люди,которые страдают различными аллергическими реакциями и им нельзя лечиться обычными препаратами.
Гомеопатические средства для лечения имеют довольно разную стоимость,иногда она выше за цену препаратов из обычной аптеки,а иногда совсем наоборот.
Гомеопатические средства немного отличаются от привычных нам химических лекарств. Почему? Все очень просто. Гомеопатические препараты-это группа веществ,которые имеют полностью натуральный состав. Как правило,они не лечат симптомы и саму болезнь, а помогают организму справиться с болезнями самостоятельно. Но без применения таких препаратов человеку очень сложно побороть какую нибудь даже хроническую болезнь.

Гомеопатические препараты можно купить не только в аптечном киоске,но и заказать в интернет-магазине.
Московский гомеопатический центр
Московский гомеопатический центр расположен по улице Владимирской, 2 (номер два). Также есть официальный сайт данного центра,где можно не только приобрести какой-нибудь гомеопатический препарат,но еще и найти поклонников и друзей,приятно пообщаться в чате,обсудить волнующие вас проблемы, поделиться своими знаниями и мнением и не только.
Люди начали лечиться гомеопатическими препаратами больше 200 (двухсот) лет назад. Этот метод долгое время исследовали и нашли его хитрость-все дело оказывается в том,что обычное лекарство только подавляет симптомы болезни, а нам кажется,что мы от нее совсем избавились. А гомеопатический препарат дает человеческому организму толчок к лечению и борьбе с заболеванием. То есть у человека активизируются свои природные способности побороть заболевание. Это очень похоже на выработку антител после прививания. Но это совсем не то. Таким образом,принимая гомеопатические препараты вместо обычных привычных нам,мы лечим не заболевание, а свой организм от заболевания. Гомеопатия регулирует процесс борьбы с болезнями.Точнее,помогает в этом нашему организму,поскольку процесс излечения регулируется по сути самим организмом. Интересно?

Такие препараты обрели огромную популярность,поскольку они практически безвредны и с их помощью можно лечить маленьких деток,стариков, беременных женщин, при этом не вызывая совершенно никаких побочных эффектов.
Препараты данной группы отпускаются без рецепта, многие доктора не уверены до сих пор в их эффективности и положительном влиянии на организм. Но это бизнес как-ни-как, и все это понимают. Сейчас у каждого врача есть связь с аптекой,куда он посылает своих пациентов и имеет свой дополнительный доход к заработной плате.
Если вы выбрали для своего лечения гомеопатический метод, то страховку вам не оплатят.

Самыми популярными гомеопатическими препаратами являются средства от простудных заболеваний,таких как кашель,бронхит, синусит, мигрени, депрессия,и даже от онкологических заболеваний. В таком лечении лежит принцип:подобное лечится подобным.
Московскому гомеопатическому центру в этом году выполнилось 80 (восемьдесят) лет.
Если хотите задать вопрос по препаратам или записаться на прием или консультацию к доктору этого центра, то звоните по таким телефонам: (495)672-26-95 (четыреста девяносто пять,шестьсот семьдесят два,двадцать шесть, девяносто пять), (495) 672-28-95 ( четыреста девяносто пять,шестьсот семьдесят два,двадцать восемь, девяносто пять), (495) 672-26-87 ( четыреста девяносто пять,шестьсот семьдесят два,двадцать шесть, восемьдесят семь)-это детское отделение, (495) 795-11-07 ( четыреста девяносто пять,семьсот девяносто пять, одиннадцать,ноль семь)-аптека.
Многоученых расценивают гомеопатию как псевдонауку, и лечение от нее сводится к нулю. Но в каждого свое мнение.

Каждая женщина мечтает о эффективном похудении, но не каждая знает о способах для снижения веса, мечтая про таблетки для похудения, которых сегодня достаточно много. Даже аптеки реализуют средства, которые могут помочь снижать вес. Препарат Сиофор является одним из таких средств, но продается оно исключительно как лекарственное средство для больных диабетом и прочих заболеваний, в следствии которых появляется избыточная масса тела. Но даже этот факт не останавливает женщин и они пробуют такой вариант для снижения веса. Но не все получают то что хотят, многие получают побочные действия лекарственного препарата, что совершенно не странно. В этой статье, мы рассмотрим подробнее что такое сиофор, насколько это действенное средство.
Где можно купить препарат Сиофор, стоимость средства
Препарат Сиофор можно купить только в аптеках, его не стоит покупать в интернете и тем более не стоит покупать средство из рук, его покупать можно только в аптеках где есть сертификаты. Стоимость одной упаковки препарата составляет порядка 500 рублей, одной упаковки препарата хватает на полноценный курс применения средства. В интернете много отзывов о средстве, от людей которые лечились с помощью сиофор, но есть отзывы и от тех, кто худел с помощью этого препарата. Многие описывают массу побочных реакций от препарата, описывают массу негативных сторон после применения и это не удивительно, поскольку это лекарственное сильнодействующее средство. Теперь подробнее рассмотрим о действии препарата сиофор и его эффективности.
Что такое сиофор, как работает средство
Сиофор средство которое выписывают для больных диабетом. Это достаточно сильный лекарственный препарат, который полностью меняет обмен веществ во всем организме человека. Это средство действительно очень серьезное, если его неправильно применять, то можно навредить своему здоровью, и проблемы могут насколько серьезными, что есть риск попасть в кому от приема Сиофора. Кроме этого, средство оказывает сильное воздействие на почки и печень, может вызывать серьезные проблемы с ними. Безусловно, эффективность препарата во время снижения веса колоссальная, но как бы не хотелось похудеть, без указаний и рецепта врача, не рекомендуется принимать Сиофор. Кроме того, дозировка препарата бывает разной, определить какая именно дозировка необходима вам, может исключительно врач.
Дозировка препарата выпускается по 500 и 850 миллиграмм, в расчете на безопасное похудение. Безопасным похудением может быть только 1-2 килограмма в неделю, не более. Есть дозировка в 1000 мг, при обычном похудении без заболеваний, такую дозировку не рекомендуется использовать. Можно сказать, что препарат может быть использован как средство для похудения, но худеть стоит только с помощью врача, но простое похудение не является основным показанием для регулярного приема средства. Стоит быть крайне осторожным с приемом средства, чтобы не навредить своему здоровью, а принести положительный эффект во время снижения веса с помощью Сиофор.
Отзываются люди про средство по разному. Большинство из них говорят о положительном эффекте снижения веса без побочных реакций, но много людей говорят о постоянных головных болях, о тошноте, о боли в печени. Рекомендует препарат к приему всего 20%, остальные говорят что худеют, но здоровье от этого слишком страдает. Теперь стоит подумать, зачем использовать Сиофор, который за месяц помогает устранить не более 8 килограммов, но столь сильно влияет на здоровье и внутренние органы?
Лучше заняться спортом, испробовать специальное питание, здоровое и сбалансированное, приняться за физические упражнения. Можно выбрать очищающий мочегонный чай для похудения, выпивать в сутки максимальное количество воды. Это все только наладит здоровье, поможет улучшить его, омолодит организм и внешний вид человека. Так что, прежде чем вы решитесь на прием Сиофор, 200 раз подумайте перед этим, вам нужно крепкое здоровье или все же плохое но в худом теле.

Самоздрав?
Ну да ладно? Ничего по-оригинальней не нашлось? Ну хорошо, эту претензию вы можете рассматривать, как претензию на ровном месте, но мне все равно кажется, что можно было бы и посидеть над названием чуть больше, чем пару минут. Я часто упоминаю гомеопатию в своих статьях и обзорах на различные странные или не внушающие доверия аппараты или препараты, но к дыхательным тренажерам у меня такое же странное отношение, как и заявление о том, что сахарные шарики могут лечить рак. Я отлично знаю, что йоги часто практикуют различные дыхательные упражнения, мол это очень хорошо влияет на здоровье ваших дыхательных путей и легких в целом. Даже некоторые исследования доказывают положительное влияние таких упражнений, но конечно же они доказывают что-то, ведь, насколько я знаю, дышать - полезно. Но именно к этому аппарату я отношусь и буду относиться с огромной долей скепсиса, ведь производитель заверяет, что этот аппарат лечит всевозможные заболевания, даже заболевания желудка. На мой взгляд, такие аппараты вообще не способны лечить что-либо, разве что они могут немного уменьшить тягу их производителей к деньгам. Да, как вы можете уже заметить, этот обзор-отзыв далеко не нейтральный. А суть вся в том, что меня очень выводит из себя, когда люди, конкретные мракобесы, пытаются выдать свои "инновационные изобретения" за лекарства или методы лечения всех болезней. Чтобы вы понимали, некоторые из них считают, что ношение очков - это вредная привычка, с который надо бороться на ровне с алкоголизмом и курением, один из методов избавления от такой "привычки" - это многократные упражнения, которые заключаются в том, что вам нужно на протяжении какого-то времени смотреть на СОЛНЦЕ. Вот у вас тоже еще не появилась мысль о том, что таким людям просто нельзя верить?
Ну ладно, давайте посмотрим
Если вы все еще хотите верить этим людям, тогда сейчас я постараюсь вам в этом сильно разуверить. Хорошо, гомеопатия, плацебо и так далее для вас просто слова? Опять я хочу обратиться к голым фактам эти факты никак не опровергаются самим производителем Самоздрава, а этот факт, который вызывает у меня бурю не очень приятных эмоций заключается в том, что ваш организм буквально насилуют. Знаете, раньше в детстве многие любили зарываться под одеяло и начинать под ним дышать, чтобы нагреть постель или просто получить такой своеобразный "приход"(наверное приход было слишком громко сказано, но не суть). Легкое головокружение, не способность сконцентрироваться на чем-то, все это последствия наличия большого уровня CO2 в крови. Конечно же это не влияло положительно на ваш организм, ведь человек не приспособлен к тому, чтобы дышать CO2. Именно поэтому он и не усваивается организмом, а проходя с воздухом в легкие просто выходит обратно. Но наши гении, просто непризнанные нобелевские лауреаты считают, что наоборот, чем больше и чем дольше вы будете дышать CO2, тем здоровее вы будете. А те их заверения, что у всех людей слишком низкий уровень CO2 в крови, ничто иное как бред. Это не слишком сложно найти в интернете информацию о том, что в человеческом организме достаточно CO2, а в больших городах его даже слишком много. Дело в том, что производители Самоздрава решили огласить протест системе, они, скорее считаю, что все исследования авторитетных групп являются фикцией, весь мир против них и только ни обладают этим самым сакральным знанием. Напоследок хотелось бы посоветовать вам никогда не верить мракобесам, проверяйте факты и доверяйте только авторитетным источникам. Не спонсируйте мракобесие и следите за своим здоровьем!




В таблетках
Многие страдают аллергическими реакциями, которые не получается во время остановить и блокировать. Есть хороший препарат который по своим фармакологическим показателям подойдет всем без исключения. Это таблетки Кларидол.
К тому же средство обладает противовоспалительным эффектом и снимает зуд и предотвращает отеки кожи и тканей внутри.
Препарат имеет много аналогов и считается импортным и безвредным для употребления, так как быстро всасывается в желудочно-кишечный тракт и выходит с мочой не влияя на почки и печень.
По показаниям подойдет как детям так и взрослым с хроническими ренитами, с кропивницей, и трудными отеками и аллергиями например после укуса комаров и пчел.
Минус в том что нельзя применять в детском возрасте до двух лет. А также людям склонными к гиперчувствительности и также в период беременности и лактации нельзя принимать данный препарат в форме выпуска таблеток. Есть Кларидол и в форме выпуска геля, который мы рассмотрим ниже в нашей статье и рассмотрим его показания и противопоказания и сможет четко понять его цену и преимущество над другими средствами противоаллергического действия. Купить его можно как на сайте так и во множествах аптек разных стран.
Гель
А вот гель считается биологически активной добавкой которая легко помогает справиться с папилломой вируса человека и широко данное средство применяется в России и за рубежом также.
Буквально с первого момента использования средства снижается риск развития новообразования и преобразования его в злокачественную опухоль. Снимает зуд и покраснения уменьшает. наросты и способствует быстрому заживлению ран.
Вирус папилломы человека очень опасен и почти 99 процентов людей о нем и не подозревают. Именно данный гель не только внешне избавит вас от симптомов папиллом но и купирует вирус внутри без болей и без врачебного или хирургического вмешательства.
Преимущества средства в том что оно не имеет в составе химии а только состоит из растительных компонентов с добавками минералов, витаминов и комплексов аминокислот. Данный препарат очень прост в использовании его можно наносить на разные участки кожи и также его можно использовать не ограничено.
В составе есть дистиллированная вода, а также пантенол который и успокаивает кожу.
Данный препарат не имеет похожих средств, поэтому так цениться теми кто им пользуется ведь хватает средства на долго.
Препарат прошел все тесты контроля качества и одобрен дерматологами .
Цена и отзывы
Отзывая о препарате клиенты говорят что подходит всем вне зависимости от пола и от возраста, подходит и старикам тоже.
Многие отзываются о хорошем и понятном составе и о том что есть инструкция на русском языке.
Также хорошие и положительные отзывы идут от тех кто заказал это средство в маленьком городе. Ведь папиллома вирус человека больше проследует именно людей из сельской и маленькой местности и поэтому такой препарат можно заказать по одинаковой цене для всех точек и стран мира.
Сайт вы найдете быстро на первых страницах поисковых систем.
Важно заказывать средство именно на официальном сайте так как есть много подделок, а гарантии качества только у средства кларидол. И так примерная цена для России это 999 рублей, для Украины 399 гривен.
В общем есть средство похожее аптечное кларидол, а то что сайте это клареол, но и то и то снимает аллергические реакции и действует как всем известный ларотодин. Только разница в колоссальной цене.
Делайте выбор в пользу натуральности средства и доступности, ведь именно каридол обладает действием трехфазовым и только этот препарат доступен сегодня по акционной цене. 

Сегодня достаточно много людей страдают никотиновой зависимостью, от которой наиболее сложно избавляться на психологическом уровне. Начинать курение легко, а вот его закончить практически не реально, поэтому всего лишь небольшой процент курильщиков могут избавиться от пагубной привычки по собственному желанию. Другие ищут способы которые помогут избавиться от зависимости, к счастью таких способов достаточно много, которые активно и эффективно помогают избавляться от никотиновой зависимости. Одним из таких средства являются жевательные резинки Никоретте. Поэтому, в нашей сегодняшней статье, мы более детально рассмотрим, действительно ли эти жевачки способный помочь бросить курить и насколько они безопасны для здоровья человека. 
Где купить никоретте
Купить эти жевачки сегодня можно практически в любой аптеке, запрета на продажу данного средства нет. Это средство является лекарственными, поэтому с его помощью вы проходите курс лечения который помогает избавиться от никотиновой зависимости. Данный препарат далеко не из дешевых вариантов, его цена составляет порядка 1200 рублей за упаковку, но препарат действительно действенный и в короткие сроки помогает избавиться от тяги к курению. При этом, к этому препарату имеются всевозможные лицензии и сертификаты качества, ведь в аптеках без подобных документов вам не продадут ни одно лекарство. Не стоит покупать этот препарат в интернете, Вы можете купить подделку которая окажется малоэффективной. Теперь же, рассмотрим что такое жвачка никоретте и действительно ли она эффективна. 
Что такое никоретте
Никоретте - это жевательные резинки которые эффективно снижают тягу к курению бес какого либо дискомфорта, возникающего при отказе от этой пагубной привычки. На сегодняшний день это самый прекрасный и наиболее эффективный препарат, который без сложностей устраняет никотиновую зависимость.
Возможно многие осудят тот факт, что в составе этого препарата находится никотин, но с помощью этого фактора человеку получается намного быстрее избавиться от вредной привычки. Никотин активно проходит через слизистую рта, никотин из жевательной резинки способен оказывать такое же самое действие, которое оказывает выкуренная сигарета. Но его воздействие намного сильнее, поэтому всего лишь одной жвачки хватит на несколько часов, когда сигарет за 2 часа человек может выкурить около 5. При этом, такая жевачка совершенно не вызывает никакой привычки, она со временем полностью избавляет человека от зависимости, затем человек легко может отказаться и от самой жевачки. Кроме никотина в данном препарате содержатся и другие вещества, поэтому перед применением его, нужно прочитать детальную инструкцию и ознакомиться со всеми противопоказаниями и показаниями. 
Как использовать
В приеме этого средства нет ничего сложного, но в сутки человек должен получать не более чем 15 пластинок. Дозировка определяется индивидуально, если человек может быстрей отказаться от никотина, дозировку препарата можно сократить от 15 до 7. Курс лечения этим препаратом заключается в 12 неделях, по истечении 12 недель человек полностью отказывается от никотина и больше не хочет курить. Некоторые от сигареты отказываются раньше и прекращают лечение с помощью никоретте. В любом случае 90% из 100 которые попробовали данный препарат с легкостью избавляются от никотиновой зависимости, это достаточно хороший показатель. Так что, не смотря на дорогую стоимость, наши рекомендации никоретте получает, этот препарат обладает действительно хорошими свойствами и эффективностью, эти жевачки не вредят человеку, они правда довольно-таки хороши.

Каждая женщина прекрасно знает о том, что красота ее волос - это один из самых важных пунктов во внешнем виде женщины. За волосами необходимо правильно ухаживать и уделять им очень много внимания, поскольку волосы достаточно часто подвергаются различных внешним факторам, которые негативно сказываются на их состоянии. Многие ухаживают за волосами в домашних условиях, но те кто поздно кинулся, бегут к стилистам и парикмахерам за помощью, чтобы вернуть волосам былую красоту. Наиболее распространенной процедурой по восстановлению волос сегодня, является кератиновое выпрямление волос. Данная процедура не просто так популярна, ведь с ее помощью удается вернуть волосам красоту. Именно поэтому, более подробно о процедуре и ее эффективном воздействии, мы расскажем далее в нашей статье.
Что такое кератиновое выпрямление волос
Кератиновое выпрямление волос - это достаточно эффективная процедура для восстановления красоты волос и соответственно их восстановления. С помощью данной процедуры, удается восстановить волосы, даже если они слишком повреждены, удается обрести объем и гладкие блестящие волосы на несколько месяцев. И это не просто обещания, как к примеру обещания на шампуне от производителя, это действительно максимально эффективная процедура. Проводится кератиновое выпрямление волос исключительно в салоне, профессиональным стилистом, который знает как правильно проводить процедуру и обладает действительно хорошим запасом средств для кератинового выпрямления.
Кератиновое выпрямление волос, обеспечивает максимальное лечение волос, восстанавливая их при самых запущенных случаях. Каждая волосинка на голове женщины, состоит полностью из из кератина, но случается так, что этот компонент волос теряет и становится сухим и не послушным. Кератиновое выпрямление волос, помогает снова насытить волосы кератином, делая волосы снова красивыми и совершенными и происходит это как только, специалист снимает состав с волос и сушит их, невозможно не наслаждаться эффектом который происходит с помощью этой процедуры.
В домашних условиях процедуру можно провести, но стоит купить специальные средства для этого и изучить поэтапное нанесение средств на волосы. Не стоит рассчитывать на то, что кератиновое выпрямление получиться с помощью дешевого желатина, это совершенно не так. Желатин обладает массой полезных свойств, но никогда не выпрямит волосы так, как салонная процедура. Безусловно, это не дешево, примерная цена в салоне среднего класса, составит порядка 4000-5000 рублей. Но стоит помнить о том, что эффект способен продержаться порядка 3 месяцев. Теперь рассмотрим подробнее, как проводиться процедура и какого эффекта ожидать.
Как проводиться процедура кератинового выпрямления волос
Процедура кератинового выпрямления волос занимает около трех часов. Специалист пошагово производит восстановление волос, наносят на волосы специальные составы, которые проникают в структуру волосинки, которые окутывают каждую волосинку, делая ее более толстой, прибавляя шевелюре более густой объем. Эффект после проведения процедуры способен продержаться более чем три месяца, что достаточно много для салонной процедуры, но следует соблюдать несколько правил, чтобы не повредить волосы, не выпрямлять их, не подвергать термическим обработкам.
После кератинового выпрямления волосы станут ровными, прямыми, красивыми и блестящими. Поэтому, даже не стоит думать, нужно вам это или нет, ведь даже с самых сухих волос такая процедура способна сделать невероятно красивые и блестящие волосы, без какого либо вреда для них.

Бабезиоз
Бабезиоз - клещевое заболевание, напоминающее малярию, вызванное разновидностями интраэроброцитарного простейшего бабеза. Люди являются оппортунистическими хозяевами для бабеза, когда их кусают нимфы или взрослые клещи. В настоящее время инфекция Бабезиоз передается различными клеточными векторами в Европе, Азии и северо-западных и северо-восточных Соединенных Штатах. Человеческий бабезиоз представляет собой зоонозную инфекцию, при которой клещи передают организмы бабеза из резервуара позвоночных человека. Инфекция является случайной у людей. Основными видами бабеза, являются те, которые заражают крупный рогатый скот, лошадей, собак, а также коше и мышей.

Виды и организмы этого заболевания имеют международное распространение, паразитируя на эритроцитах диких и домашних животных. Эти паразиты обычно называют пироплазмами из-за грушевидных форм, обнаруженных в инфицированных эритроцитах (эритроцитах). Большинство человеческих младенческих инфекций вызваны B тейлериями (найден только в Соединенных Штатах) или B дивергенс (найден только в Европе). Человеческий бабезиоз встречается нечасто и встречается в ограниченном географическом положении. В Соединенных Штатах, это обычно бессимптомная инфекция у здоровых людей. Несколько групп пациентов становятся симптоматическими, и в этих субпопуляциях происходит значительная заболеваемость и смертность. Болезнь сильнее всего поражает людей пожилого возраста, с ослабленным иммунитетом или аспленических.
Диагностика заболевания
Бабезиоз трудно диагностировать. Хотя индекс подозрения должен быть высоким в районах, эндемичных для инфекции бабеза, у людей с бабезиозом мало признаков, чтобы выявить данное заболевание. Подтверждение диагноза зависит от степени паразитемии и опыта персонала больницы, в которую вы обратились. Большинство инфицированных людей, которые в других отношениях здоровы, по-видимому, имеют умеренное заболевание и обычно восстанавливаются без специальной химиотерапии. Тем не менее, лечение рекомендуется во всех диагностированных случаях, чтобы предотвратить осложнения и потенциальную передачу через донорство крови. Кроме того, людям следует рекомендовать принять меры предосторожности против воздействия клещей и воздерживаться от сдачи крови до полного излечения от бабезиоза.
Прогноз заболевания
Бабезиоз имеет спектр тяжести, который может быть разделен на 3 отдельных части следующим образом: бессимптомная инфекция, синдром слабого или умеренного вирусного типа, тяжелая болезнь с молниеносным течением, приводящим к смерти или стойкому рецидиву.

Бабезиоз у здоровых людей вызывает острое инфекционное заболевание, напоминающее малярию. В большинстве случаев бабезиоз является субклиническим или слегка симптоматическим. Бабезиоз может продолжаться более 2 месяцев после лечения. Бессимптомные инфекции могут сохраняться в течение нескольких месяцев. Люди с положительными мазками или положительной полимеразной цепной реакцией дают результаты более чем через 3 месяца после того, как исходное лечение следует повторить, независимо от наличия или отсутствия судорог.
У здоровых лиц с интактной селезенкой бабезиоз редко бывает фатальным. Однако, у людей, которые являются аспленическими, бабезиоз, как правило, довольно тяжелый и связан с существенной смертностью. У людей с асфиксией наблюдается более стремительный и длительный клинический курс, и у них может быть подавляющая инфекция, приводящая к смерти. Симптомы, испытываемые этими людьми, являются более серьезными симптомами и длятся дольше, чем те, которые наблюдаются у людей, у которых либо есть одна болезнь.

Пора бы уже
Здравствуйте, дорогие читатели. И сразу хочу начать свой отзыв-обзор с лирического отступления. Так получилось, что я очень много и достаточно часто писал отзывы на гомеопатические препараты, я пытался донести до общественности всю правду про эти "чудодейственные" препараты, иногда это получалось, иногда не очень. И в какой-то момент руки начали опускаться. Когда все адекватно мыслящие люди не признают гомеопатию, а правительство и различные мракобесы это активно пропагандируют и финансируют и, когда это все действительно пользуется огромной популярностью, невольно задумываешься - "А зачем вообще что-то разоблачать? Зачем вообще что-то пытаться донести?". Мол я же сам все отлично понимаю, а чем лечить себя - это выбор каждого. Но потом понимаешь, что на самом деле - нет. Ведь я не заставляю кого-то не пользоваться чем-то. Я просто занимаюсь популяризацией не очень популярных идей и суждений( именно в нашей стране ), в других же, развитых странах, все, что я высказываю по поводу гомеопатии, поддерживается и не просто поддерживается на словах, это все подкрепляется исследованиями над этими гомеопатическими препаратами, которые в итоге не дают никакого результата, если не брать в расчет эффект плацебо, единственный фактор, который до сих пор позволяет гомеопатам держаться на плаву. Потому что из-за пропаганды люди уверяют себя в том, что этот препарат действует и эффект плацебо действительно так работает, но чаще всего такие эффекты наблюдаются только с психосоматическими болезнями, которые вызваны самовнушением человека. Но сегодня речь пойдет не об одном из таких препаратов. Сегодня я бы хотел, наконец-то, поговорить про действующий препарат, который реально борется с болезнями, которые не смогут победить гомеопатические препараты, так как самовнушением здесь уже не обойдешься, приходится лечить реальные симптомы. Так вот, сразу же хочу сказать, что по поводу употребления данного препарата вы должны проконсультироваться у врача и никак иначе! Самолечение, тем более таким препаратом, может очень плохо сказаться на вашем здоровье, а иногда даже привести к фатальным последствиям. А препарат, который сегодня попал на мой обзор - это средство от папиллом, герпеса, гепатита и гриппа. Препарат называется - Аллокин-альфа.
С чем его едят
На самом деле - его не едят. Препарат поставляется в виде порошка в специальных ампулах, который надо будет разводить в физ растворе. Уколы осуществляются в бедро или плечо, но конечно же менее болезненно будет вводить его в бедро. Вот так работают настоящие лекарства. Кстати, отпускают лекарство только по рецепту, так что вам в любом случае придется пройти обследование у врача, тем самым вы лишаете себя риска на осложнение из-за неправильного лечения. Это лекарство выписывается людям, больным: папилломами, герпесом и гепатитом, в качестве лекарства от гриппа данный препарат выписывают крайне редко. Дело в том, что при попадании в организм действующее вещество - аллоферон, стимулирует работу иммунных клеток-убийц, которые, в свою очередь уже, убивают вирус. Данный препарат считается очень действенным, потому что от всех болезней, перечисленных мной, кроме гепатита, он избавляется за пару инъекций, а вот, если вы больны гепатитом типа B, тогда вам придется пройти курс лечения, который включает в себя инъекции данного препарата через день. Если вы столкнулись с такими проблемами, тогда точно поинтересуйтесь у своего врача по поводу данного препарата. Я могу его советовать, но конечно же желаю вам никогда не сталкиваться с такими проблемами.




Конский возбудитель для женщин???...)))
Всем привет!!!))) Сегодня я бы хотела поделиться с вами мнением о пикантной,интимной теме,о возбудитель для женщин. Действительно ли способен конский возбудитель для женщин помочь для них в интимном вопросе,это актуальный вопрос для женщин,которые этим интерисуются)).На сегодняшний день действительно очень много различных реклам об этом и других подобных средствах, но многие материалы, которые публикуются в интернетах, журналах они являются не достоверными и не смогут подойти каждой, ведь каждая женщина индивидуальна. Но давайте разберемся более подробнее о конском возбудителе.)) Это средство используют ветеринары при случке крупного рогатого скота и если девушка, женщина без каких-либо консультаций с доктором и так далее начнет применять данное средство, то можно легко отравиться, ведь не зная, что ты пьёшь,как и в каком количестве,но всё же в аптеках можно найти средство, которое предназначается именно для людей, оно идёт на основе вытяжки тестикулярной сыворотки,его можно приобрести в аптеках и секс шопах,и называется —ВТС, вытяжка тестикулярной сыворотки.И именно этот препарат способен подействовать на сексуальное возбуждение, он выпускается в виде капель, применять во внутрь. Всё зависит от того какой вес женщины, которая будет принимать данный препарат. Но перед тем как вы решитесь попробовать данный препарат все-равно проконсультируйтесь с вашим доктором,во избежание побочных эффектов. Результаты данного препарата может длится на протяжении двух-трех часов и наступает уже после пятнадцати минут как вы его применили. Стоимость около одной тысячи рублей.
Ну это вещь индивидуальная, поэтому советовать его или нет я не могу, ведь каждый организм может отреагировать по-разному.Если вы захотите применить на себе конский возбудитель, то помните никаких экспериментов не проводилось и поэтому за его результат никто не несёт ответственность, и за побочные действия тем более.На одних может подействовать,а на вторых наоборот, ведь там в основе вещества, которые оказывают действие на центральную и вегетативную нервную систему, таким образом усиливая кровоток к половым органам,что соответственно и приводит к быстрому сексуальному возбуждению. В таком важном,интимном плане выбирать должен каждый индивидуально,ведь люди разные и организм у каждого так же разный!!!)))


Болеть никто не хочет и не любит. Против многих заболеваний существуют прививки, как профилактика заболевания. Против воспалительных заболеваний легких тоже есть такая мера профилактики.
Существует такая французкая вакцина для предотвращения пневмококковых инфекций, называется она "Pneumo 23", производитель "Санофи Пастер".
Вакцина уже готова к употреблению, она находится в одноразовом шприц-тюбике. Он не большой, потому что вакцина всего 0,5 мл . Шприц упакован в индивидуальную упаковку, а сверху в картонную коробку.
Название вакцины говорит само за себя. Если расшифровать его, то получится, что в состав вакцины входят капсульные очищенные полисахариды Streptococcus pneumoniae двадцати трех серотипов, которые вызывают самые распространенные пневмококковые заболевания, а также которые наиболее тяжело переносятся.
Как и любая другая вакцина, пневмококковая вакцина применяется в профилактических целях, в момент заболевания она бесполезна. Потому что организм должен выработать специфический иммунитет к инфекциям, которые были введены в него. Соответственно профилактика будет направлена на появление иммунитета к пневмококковым инфекциям различной локализации.
В основном вакцина "Пневмо 23" направлена на профилактику пневмонии, сепсиса, менингита и отита.
Работает эта прививка 5 лет, это значит, что после ее введения в организм начинает формироваться иммунитет, который будет защищать организм от инфекции до 5 лет.
Прививка пневмококковая не входит в календарь прививок, то есть она не обязательная. Поставить ее можно на платной основе, в кабинете вакцинации.
Прививку можно ставить уже с двухлетнего возраста. Это актуально для часто болеющих деток, а также для деток, которые собираются в детский сад. Многие знают, то что когда детки начинают ходить в садик, они начинают интенсивно болеть. При чем заболевания могут затягиваться, а на одну болезнь другая инфекция может присоединяться. Все это опасно тем, что могут возникать осложнения, например отит - это частое осложнение вирусных и бактериальных воспалений носоглотки. Также легкое недомогание может перейти в тяжелую пневмонию. Поэтому многие мамы, я знаю ставят такие прививки своим детям.
Взрослым также ставят прививку по желанию. Такую вакцину можно сочетать с вакциной против гриппа. Я пробовала "Пневмо 23", сказать, что не болела не могу. Болела, но не так интенсивно и реже, чем раньше. Сама прививка ставится легко. Место укола было чувствительно где то сутки, и немного недомогание общее было. В целом переносится хорошо.
Если есть возможность защитить себя, то почему бы и нет.
-
Альтернативная медицинаАльтернативная медицина(2585)
-
Как правильно бегатьКак правильно бегать(1)
-
Косметика декоративнаяКосметика декоративная(2380)
-
Косметика ухаживающаяКосметика ухаживающая(6367)
-
Косметические принадлежностиКосметические принадлежности(592)
-
Косметические процедурыКосметические процедуры(1175)
-
Лекарственные средстваЛекарственные средства(11115)
-
Методы лечения и операцииМетоды лечения и операции(1177)
-
Очки и контактные линзыОчки и контактные линзы(154)
-
Парфюмерия и дезодорантыПарфюмерия и дезодоранты(1707)
-
Разное (красота и здоровье)Разное (красота и здоровье)(14105)
-
Средства гигиеныСредства гигиены(966)
-
Средства для похуденияСредства для похудения(3470)
-
Средства контрацепцииСредства контрацепции(259)
-
Средства увеличения грудиСредства увеличения груди(29)
-
Стрижки и прически для волосСтрижки и прически для волос(215)
